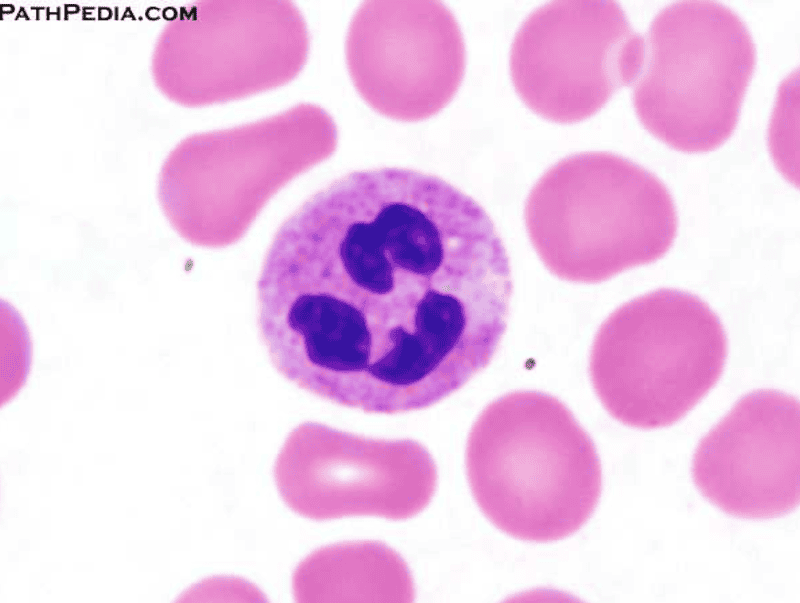

How many lobes does the nucleus of a neutrophil have?
When neutrophils have reached maturity, the nucleus can have several lobes - usually two to four. These lobes are linked by delicate strands of a nuclear nature. The position of the lobes, and of the nucleus in general, is quite dynamic. Therefore, the lobes can vary in their position and also in number.
What is the size of a neutrophil?
In the blood smears analyzed in the laboratory, it has been observed that the dimensions of the neutrophils are between 10 to 12 micrometers (µm), being slightly larger than the erythrocytes. One of the most prominent characteristics of neutrophils is the shape of their nucleus, with multiple lobes.
How many protrusions are there in the nucleus of neutrophils?
The nucleus of neutrophils is variable in terms of its morphology, which is why the cell is said to be polymorphonuclear. Generally, this nucleus has three to five irregular protrusions or lobes.
What type of cells are neutrophils?
The neutrophils They are cells of the leukocyte type and of the granulocyte subtype that participate in the immune response by phagocytizing bacteria, fungi and other potentially pathogenic entities for the body.
Are neutrophils multi-lobed?
The neutrophil nucleus has a different morphology. It is a multi-lobed nucleus where some researchers argue no longer function.
How many lobes does basophil have?
Basophils contain large cytoplasmic granules which obscure the cell nucleus under the microscope. However, when unstained, the nucleus is visible and it usually has 2 lobes.
What do you call the neutrophil with more than 5 lobes?
Neutrophil hypersegmentation can be defined as the presence of neutrophils whose nuclei have six or more lobes or the presence of more than 3% of neutrophils with at least five nuclear lobes.
What is a neutrophil with a nucleus with 6 lobes?
Hypersegmented neutrophils have 6 or more nuclear lobes. They are typically seen in megaloblastic anemia due to vitamin B12 or folic acid deficiency, but may also be present in myelodysplastic syndromes and rare congenital conditions.
How many lobes do eosinophils have?
two lobesThe eosinophil is a specialized cell of the immune system. This proinflammatory white blood cell generally has a nucleus with two lobes (bilobed) and cytoplasm filled with approximately 200 large granules containing enzymes and proteins with different (known and unknown) functions.
Do monocytes have lobes?
However, neutrophils are not the only migratory cell in circulation; circulating monocytes, for example, have a lobed nucleus but, as described below, the lobes are larger and fewer. Monocytes are also flexible enough to enter tissues, whereupon they differentiate into various other cell types including macrophages.
Which WBC has maximum lobes of nucleus?
NeutrophilNeutrophil has maximum lobes of the nucleus. These are the most abundant type of white blood cells in mammals and form an essential part of the innate immune system. They are formed from stem cells in the bone marrow.
How many lobes are in a Hypersegmented neutrophil?
Hypersegmentation. The presence of hypersegmented neutrophils is an important diagnostic feature of megaloblastic anaemias. Neutrophil hypersegmentation can be defined as the presence of neutrophils with six or more lobes or the presence of more than 3% of neutrophils with at least five lobes.
Which WBC is the largest?
Monocytes. Monocytes are the largest cells of the blood (averaging 15–18 μm in diameter), and they make up about 7 percent of the leukocytes.
How many nuclei are in neutrophils?
Normally, neutrophils contain a nucleus divided into 2–5 lobes. Neutrophils are a type of phagocyte and are normally found in the bloodstream....NeutrophilFMA62860Anatomical terms of microanatomy8 more rows
Which leukocyte has a multi lobed 3/5 lobes nucleus?
Which leukocyte has a multi-lobed (3-5 lobes) nucleus? The leukocytes consist of neutrophils, lymphocytes, monocytes, eosinophils, and basophils. Neutrophils are granulocytes. Neutrophils have a multi-lobed nucleus.
What is the structure of neutrophils?
Neutrophils have a characteristic multilobed nucleus, with 3 to 5 lobes joined by slender strands of genetic material. The cytoplasm of neutrophils contains numerous purplish granules called azurophilic or primary granules that contain microbicidal agents.
What are the 2 main types of lymphocytes?
These antigen-presenting cells subsequently migrate into lymphoid tissue. There are two major types of lymphocyte: B lymphocytes, which mature in the bone marrow; and T lymphocytes, which mature in the thymus. The bone marrow and thymus are thus known as the central or primary lymphoid organs.
What is absolute basophil?
Absolute basophil count: An absolute basophil count identifies how many basophils are present in a sample of your blood. The calculation for an absolute basophil count multiplies the percentage of basophils from a complete blood count by the total number of white blood cells from the same count.
How many basophils are normal?
A normal basophil count is . 5% to 1% of your white blood cell count. This equals about zero to 300 basophils per microliter of blood in healthy adults.
What does Basopenia mean?
Basopenia is the medical term for abnormally low basophil levels. When a basophil releases its granules in response to an invader or inflammation, it becomes empty.
Where do neutrophils mature?
Neutrophils are of granulocyte origin. They mature in the bone marrow and are then released into blood and tissues. Neutrophil proliferation and maturation is stimulated by granulocyte colony stimulating factor (G-CSF).
What are the roles of neutrophils?
Roles of Neutrophils. Neutrophils make up part of the innate immune system, and as such act immediately and are non-specific in their action. They migrate to a site of infection and phagocytose pathogens such as bacteria, fungi and protozoa.
What are the primary and secondary granules of neutrophils?
Neutrophils contain primary and secondary granules. The primary granules are azurophilic (Burgundy-coloured) and contain toxic mediators such as elastase and myeloperoxidase. The secondary granules are pink-staining and contain proteins such as lactoferrin; these are not usually visible by light microscopy.
What causes sequestrational loss of neutrophils?
Any condition that induces hypersplenism (including cirrhosis, certain infections, myeloproliferative disorders and chronic haemolytic anaemia), can cause sequestrational loss of neutrophils. Felty's syndrome is the triad of rheumatoid arthritis, splenomegaly and neutropaenia, and is associated with poorer prognosis in the RA patient.
What is the presence of increased circulating neutrophils?
Neutrophilia is the presence of increased circulating neutrophils, and is a common finding in the full blood count of acutely unwell patients.
What is the most common white blood cell in circulation?
Neutrophils are the most prevalent white blood cells in circulation. They are a type of polymorphonuclear (PMN) leukocyte, with 3-5 nuclear lobes and fine granules within the cytoplasm.
How many neutrophils are produced?
According to calculations, neutrophil production is in the order of 10 11 cells per day, which can rise by an order of magnitude when the body is experiencing a bacterial infection.
How many protrusions does a neutrophil have?
The nucleus of neutrophils is variable in terms of its morphology, which is why the cell is said to be polymorphonuclear. Generally, this nucleus has three to five irregular protrusions or lobes.
How are neutrophils made?
The cell that originates them is called the granulocyte-monocyte progenitor , and as its name indicates, it is the cell that gives rise to both granulocytes and monocytes.
What is the name of the cell that can generate extracellular neutrophil traps?
Generation of NETs. Neutrophils are cells that can generate what is known as extracellular neutrophil traps, abbreviated as NETs, for its acronym in English. These structures are generated after the death of the neutrophil, as a result of antimicrobial activity.
Which type of leukocytes are neutrophils?
Neutrophilia. Neutropenia. References. The neutrophils They are cells of the leukocyte type and of the granulocyte subtype that participate in the immune response by phagocytizing bacteria, fungi and other potentially pathogenic entities for the body. Among the granular leukocytes, neutrophils are the most abundant cells, ...
What is a mature neutrophil?
Mature neutrophils are characterized by a segmented nucleus. That is why some authors call these leukocytes as polymorphonuclear cells, abbreviated PMNs, for its acronym in English. Within the peripheral blood, we find two forms of neutrophils: one with a segmented nucleus and others with a band-shaped nucleus.
What causes a drop in neutrophils?
Causes associated with a drop in neutrophil levels include infections, physical agents such as X-rays, vitamin B12 deficiency, ingestion of medications, and the syndrome known as lazy white blood cell.
What are the topics of the neutrophil nucleus?
The topics include morphology of human neutrophil nucleus, maturation process and modifications of the neutrophil nucleus, neutrophil activation and chromatin modifications, causes and consequences of multi-lobulated segmented morphology, and importance of the nucleus in the formation of neutrophil extracellular traps (NETs). ...
Is the neutrophil nucleus a multilobed nucleus?
The neutrophil nucleus has a different morphology. It is a multi-lobed nucleus where some researchers argue no longer function. However, studies indicate that it is very probable the occurrence of chromatin remodeling during activation steps.
What is a blood smear with two neutrophils?
Blood smear with two hypersegmented neutrophils. Neutrophil hypersegmentation can be defined as the presence of neutrophils whose nuclei have six or more lobes or the presence of more than 3% of neutrophils with at least five nuclear lobes. This is a clinical laboratory finding. It is visualized by drawing blood from a patient and viewing ...
What is the significance of hypersegmented neutrophils?
Up to 8% of circulating neutrophils are unsegmented (‘band’ forms). The presence of hypersegmented neutrophils is an important diagnostic feature of megaloblastic anaemias. Hypersegmentation can also be seen in many other condition but with relatively less diagnostic significance.
What is the size of a neutrophil in a blood smear?
This shows a neutrophil in a blood smear. The neutrophils are 12-14 µm diameter, and so look bigger than the surrounding red blood cells. There is a single nucleus, which is multilobed, and can have between 2 and 5 lobes. The chromatin in the nucleus is condensed. This means that there isn't protein synthesis.
How big are lymphocytes?
Most of the lymphocytes are small; a bit bigger than red blood cells, at about 6-9µm in diameter, The rest (around 10%) are larger, about 10-14µm in diameter. These larger cells have more cytoplasm, more free ribosomes and mitochondria.
How many types of white blood cells are there?
There are five types of white blood cell (leucocyte). These are divided into two main classes. Agranulocytes (includes Lymphocytes and Monocytes). This classification depends on whether granules can be distinguished in their cytoplasm using a light microscope and conventional staining methods).
What does a high eosinophil count mean?
A high eosinophil blood count may indicate an allergic reaction . Eosinophils are also important in killing parasitic worms.
What is the third most common type of white blood cell?
Monocytes are the third most common type of white blood cell; about 2-10% of leucocytes are monocytes.
How to identify leucocytes in blood smears?
To identify them, you need to look for the shape of the nucleus, and compare their size, relative to that of a red blood cell. Once you have looked at the examples below - have a go for yourself - click here and see if you can identify the 'mystery' cells.
How big are eosinophils?
These cells are 12 - 17 µm in diameter - larger than neutrophils, and about 3 times the size of a red blood cell. You can see that eosinophils only have two lobes to their nucleus. These cells have large acidophilic specific granules - these stain bright red, or reddish-purple.
What is hypersegmented neutrophils?
The presence of hypersegmented neutrophils is an important diagnostic feature of megaloblastic anaemias. Neutrophil hypersegmentation can be defined as the presence of neutrophils with six or more lobes or the presence of more than 3% of neutrophils with at least five lobes. In florid megaloblastic states, neutrophils are often enlarged and their nuclei may have six or more segments connected by particularly fine chromatin bridges (Fig. 5-10). A right shift with moderately hypersegmented neutrophils may also be seen in uraemia and not infrequently in iron deficiency.40 Hypersegmentation can be seen after cytotoxic and antimetabolite treatment, especially with methotrexate, hydroxycarbamide and other drugs that induce megaloblastosis.41
Is antiparietal antibody positive or negative?
Antiparietal antibody test should be positive in pernicious anemia and negative in nutritional vitamin B 12 deficiency.
Can neutrophils shift in uraemia?
A right shift with moderately hypersegmented neutrophils may also be seen in uraemia and not infrequently in iron deficiency.40 Hypersegmentation can be seen after cytotoxic and antimetabolite treatment, especially with methotrexate, hydroxycarbamide and other drugs that induce megaloblastosis.41.
